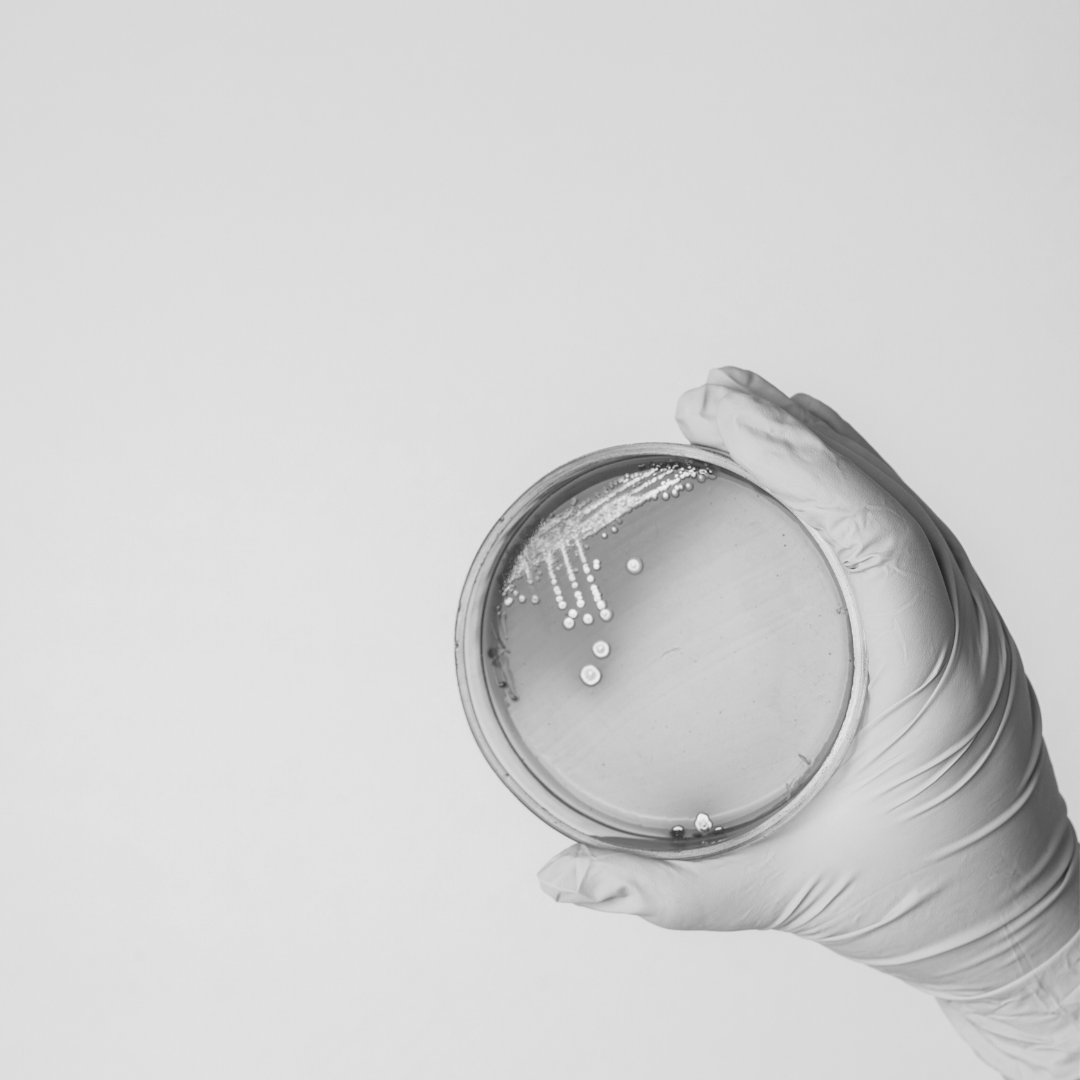

The microbiome &
SKIN SOLUTIONS

microbiome solutions
restoring balance
An imbalance in the skin's microbiome (dysbiosis) plays a significant part in many skin concerns, especially eczema and accelerated skin aging. In eczema flares, microbial diversity on the skin reduces and harmful bacteria dominate, contributing to skin irritation. Microbiome dysbiosis also accelerates skin aging, with a shift to species that promote 'inflammaging' (chronic, low-grade invisible inflammation that leads to skin aging).
Environmental factors further disrupt skin ecology (especially overuse of detergents which raise skin pH), aggravating irritation in skin conditions. Living probiotics are a new and more natural way to tackle skin conditions linked to microbiome dysbiosis. They can help manage inflammatory conditions, supporting microbiome diversity and function, for happier skin.
Staphylococcus aureus
managing eczema
Bacterial therapy
A harmful bacteria called Staphylococcus aureus is a key contributor to eczema. Up to 90% of people with eczema-prone skin have overgrowth of this bacteria and it is directly linked to the severity of eczema symptoms.
Staphylococcus aureus harms the skin barrier by (a) releasing toxins that activate inflammation, and (b) suppressing a protein that regulates barrier function.
Living probiotics are a new biome-based approach to managing eczema, using helpful bacteria to inhibit inflammation-causing bacteria. Our fermented coconut oil contains live Lactobacillus probiotics and has been scientifically validated to inhibit Staphylococcus aureus.
reducing skin aging factors
anti-aging bacteria
When we think about things that speed up skin aging, UV exposure comes to mind. But, another little known factor is microbiome imbalance.
Our skin ecosystem changes as we age, with key microbes like Lactobacillus (linked to youthful skin) declining on mature skin. The shift in microbes accelerates age-related skin changes, as pro-aging pathways like oxidative stress & collagen breakdown are activated.
Live Lactobacillus, found in our fermented coconut oil, produces potent bio-ferments that suppress skin aging factors and boost moisture in the skin, for smoother, hydrated skin.

